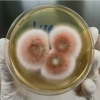

孕妇商场突然发作 众人帮忙爱心接力
2017-04-15中心医院
4月11日晚,一位怀孕9个多月的准妈妈在逛涪城万达广场时突然发作,专柜店总和营业员齐心协力应急处理,我院医务人员及时赶到搭建起“临时产房”并顺利转送我院产科。12日上午,孕妇顺产下5斤多重的男孩。15日上午,母子平安出院。在这个孕妇整个临盆过程中,众多好心人共同谱写了一曲爱心接力的好乐章。
孕妇逛商场羊水破了
4月11日晚8时30分左右,准妈妈侯女士和丈夫及3岁的大女儿一家三口在万达逛商场。突然,侯女士称肚子疼,并脸色苍白,站立不稳。商场工作人员急忙小心地把侯女士安顿到一旁的椅子上。顿时育婴店里开始忙碌起来:有的拿地垫铺在地上,有的帮助她躺下,有的用沙发垫子把她的臀部垫高以防止羊水流失过多、有的给她讲笑话转移注意力……
商场搭起了临时产房

在接到商场拨打120的急救电话后,绵阳市中心医院急救人员迅速赶往万达广场。我院产科医生邓艳梅主治医师到场后,一边组织商场工作人员用毯子、地垫搭建了一个“临时产房”保护产妇隐私,一边紧急监测胎心并做评估。邓艳梅当时做了两套紧急处置方案:产妇如不具备转运条件,就利用随行携带的急救设备进行现场接生;如果具备转运条件,就立即运回医院产科待产。万幸的是,经过商场工作人员的应急处置,目前孕妇状况平稳,具备转运条件。
孕妇顺产一5斤半男婴

晚9时45分,转运回医院的孕妇通过急救绿色通道做完相应检查后,进入产房待产。绵阳市中心医院产科为孕妇制定了详细的救治方案,进行全程的胎监和产程观察。
12日凌晨2时,孕妇临产。上午10时39分,孕妇通过顺产生下一个2840克的健康男婴,母子状况良好。
15日上午,产妇的丈夫办完出院手续,一家三口出院回家。